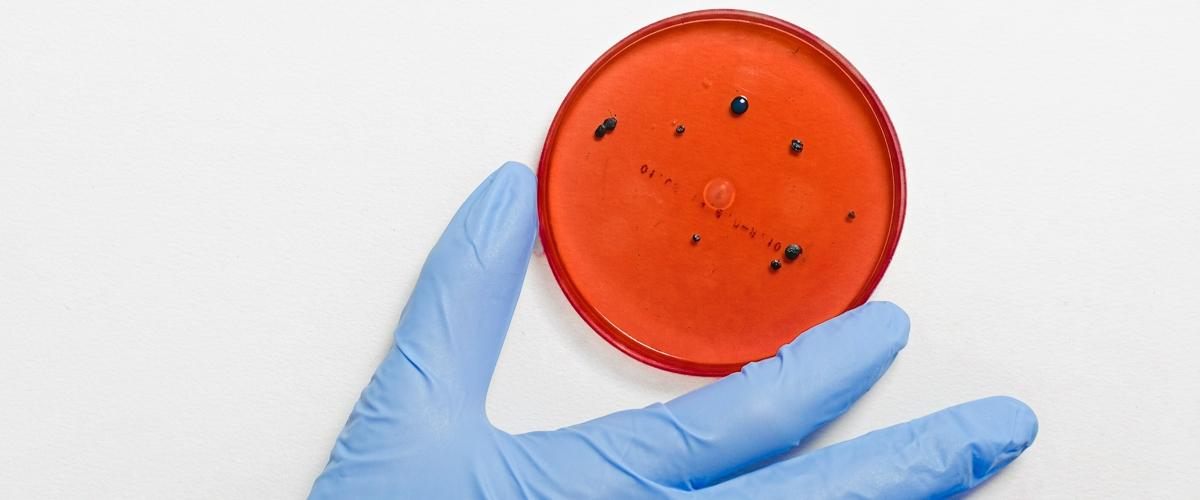
TODO:

Сейчас мир находится в состоянии войны с организмом настолько маленьким, что разглядеть его можно только в микроскоп. Но если его не остановить, в ближайшие десятилетия он убьет миллионы. И речь идет не о COVID-19, а о резистентных бактериях, пишет TechCrunch.
Сегодня в мире от бактериальных инфекций умирает 700 000 человек ежегодно. Если ничего не предпринимать, к 2050 это число возрастет до 10 миллионов, считают эксперты ООН. Проблема в том, что современная медицина прописывает слишком много антибиотиков. Кроме того, их постоянно используют в животноводстве. При этом антибиотики убивают только большинство плохих бактерий, не все. И те, кто выживают, становятся сильнее.
Американский биотех-стартап Felix считает, что нашел способ сдержать распространение резистентных бактериальных инфекций — это вирусы. Ключевая технология, разработанная его основателями, позволяет направлять вирусы в определенные места бактерий. Это не только убивает патогены, но и останавливает их способность развиваться и становиться еще более устойчивыми.
Стартап планирует в первую очередь разработать терапию бактериальных инфекций для тех, кто страдает от муковисцидоза, поскольку этим больным требуется почти постоянно принимать антибиотики, чтобы справиться с легочной инфекцией.
Felix уже успешно провел небольшое предварительное испытание своей методики на группе из десяти человек. Основатели утверждают, что их подход быстрее и дешевле, чем разработка традиционных антибиотиков, и уже работает на людях. Следующим шагом должен стать эксперимент с участием 30 человек, а затем — разработка исследовательской модели и масштабные испытания на соответствие требованиям Управления по санитарному надзору США.
Исследователи из MIT обратились за помощью в борьбе с резистентными бактериями к искусственному интеллекту. Скормив машине информацию об атомной и молекулярной структуре 2500 природных и синтезированных антибиотиков, они получили вещество, способное справиться со многими лекарственно-устойчивыми бактериями, включая возбудитель туберкулеза.